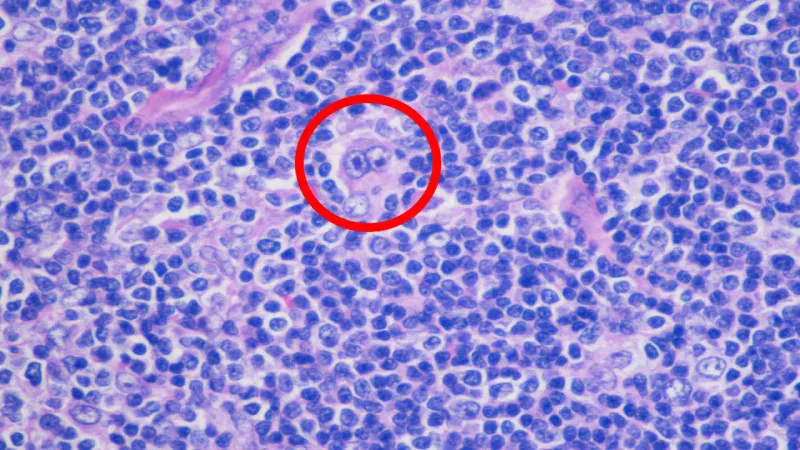
Hodgkin's Lymphoma: Reed-Sternberg cell (H&E stain)

Lymphoma Basics - The Great Divide
- Two main types: Hodgkin Lymphoma (HL) and Non-Hodgkin Lymphoma (NHL).
- Distinction is crucial for staging, treatment, and prognosis.
- Hodgkin Lymphoma:
- Characterized by pathognomonic Reed-Sternberg (RS) cells.
- Spreads contiguously (node-to-node).
- Typically presents with localized, non-tender lymphadenopathy.
- Non-Hodgkin Lymphoma:
- More common in children < 15 years.
- Spreads non-contiguously and hematogenously.
- Often presents with extranodal disease (e.g., abdominal mass).
⭐ Unlike adult lymphomas, pediatric lymphomas are overwhelmingly aggressive (high-grade) and disseminated at diagnosis.
Hodgkin Lymphoma - The Orderly Owl
- Epidemiology: Bimodal age distribution (15-30 yrs & >55 yrs); adolescent peak is key in pediatrics. Strong association with Epstein-Barr Virus (EBV).
- Clinical Presentation:
- Painless, firm, rubbery lymphadenopathy (commonly cervical, supraclavicular).
- Spreads contiguously (orderly) to adjacent lymph node chains.
- B Symptoms: Unexplained fever >38°C, drenching night sweats, weight loss >10% over 6 months.
- Diagnosis: Lymph node biopsy is essential.
- Pathognomonic finding: Reed-Sternberg (RS) cells.
- RS cells are large, binucleated cells with prominent eosinophilic nucleoli, giving an "owl-eye" appearance.

⭐ Nodular Sclerosis is the most frequent histological subtype in the pediatric and adolescent population.
Non-Hodgkin Lymphoma - The Wild Bunch
⭐ Burkitt lymphoma is the most common type of pediatric Non-Hodgkin Lymphoma.
Represents ~60% of childhood lymphomas. More common in males. Characterized by rapid, aggressive growth and extranodal spread.
- Clinical Presentation: Depends on subtype. Abdominal pain/mass, jaw involvement, lymphadenopathy, or mediastinal compression (SVC syndrome).
- Diagnosis: Biopsy is essential. Staging is done using the St. Jude/Murphy Staging system.
- Treatment: Aggressive multi-agent chemotherapy leads to high cure rates (>80%).
| Subtype | Key Features | Common Site(s) | Genetics |
|---|---|---|---|
| Burkitt Lymphoma | Fastest growing human tumor. "Starry sky" histology. Associated with EBV. | Abdomen (ileocecal), Jaw | t(8;14) c-myc gene |
| Lymphoblastic | T-cell origin (~90%). Clinically similar to T-ALL. | Anterior Mediastinum | - |
| Large Cell (ALCL) | Anaplastic Large Cell Lymphoma. "Hallmark" cells. | Skin, Nodes, Bone | t(2;5) ALK gene |
Staging & Strategy - The Battle Plan
- Staging Systems:
- Hodgkin Lymphoma (HL): Ann Arbor system.
- Non-Hodgkin (NHL): St. Jude/Murphy system is preferred; better for extranodal disease.
⭐ St. Jude/Murphy staging is crucial for Burkitt Lymphoma, as it separates resectable (Stage I/II) from unresectable (Stage III) abdominal disease.
- Treatment Principles:
- Backbone: Systemic, multi-agent chemotherapy.
- Radiation: Used selectively for bulky disease or sanctuary sites to minimize long-term effects.
High‑Yield Points - ⚡ Biggest Takeaways
- Non-Hodgkin Lymphoma (NHL) is far more common in childhood than Hodgkin Lymphoma.
- Hodgkin Lymphoma classically shows a bimodal age distribution and is defined by pathognomonic Reed-Sternberg cells.
- Burkitt Lymphoma, a high-grade B-cell NHL, is strongly associated with EBV and shows a "starry sky" pattern on histology.
- Lymphoblastic Lymphoma frequently presents with a supradiaphragmatic (mediastinal) mass and can overlap with T-ALL.
- Staging systems differ: Ann Arbor for Hodgkin vs. St. Jude/Murphy for NHL.
Unlock the full lesson and continue reading
Signup to continue reading this lesson and unlimited access questions, flashcards, AI notes, and more